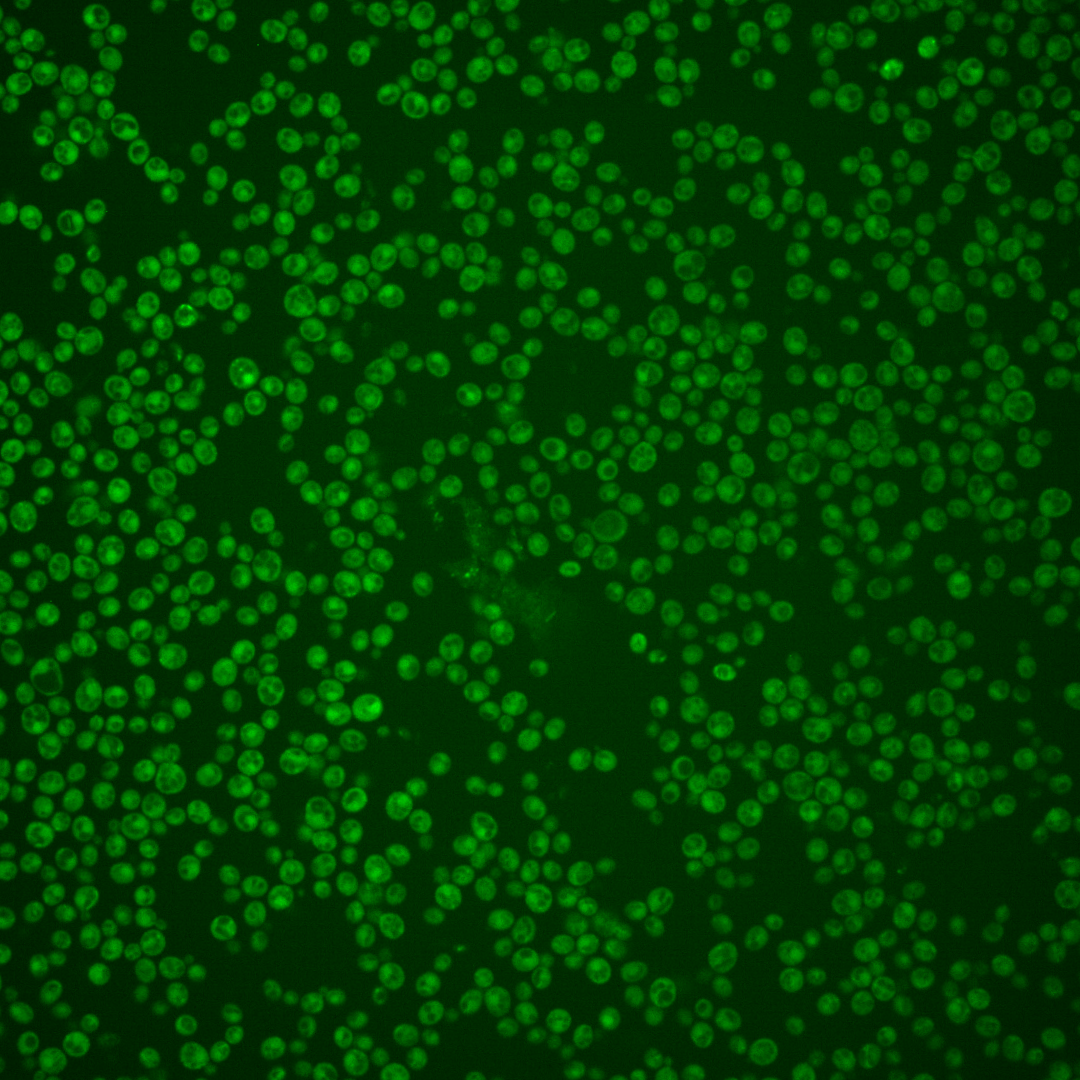
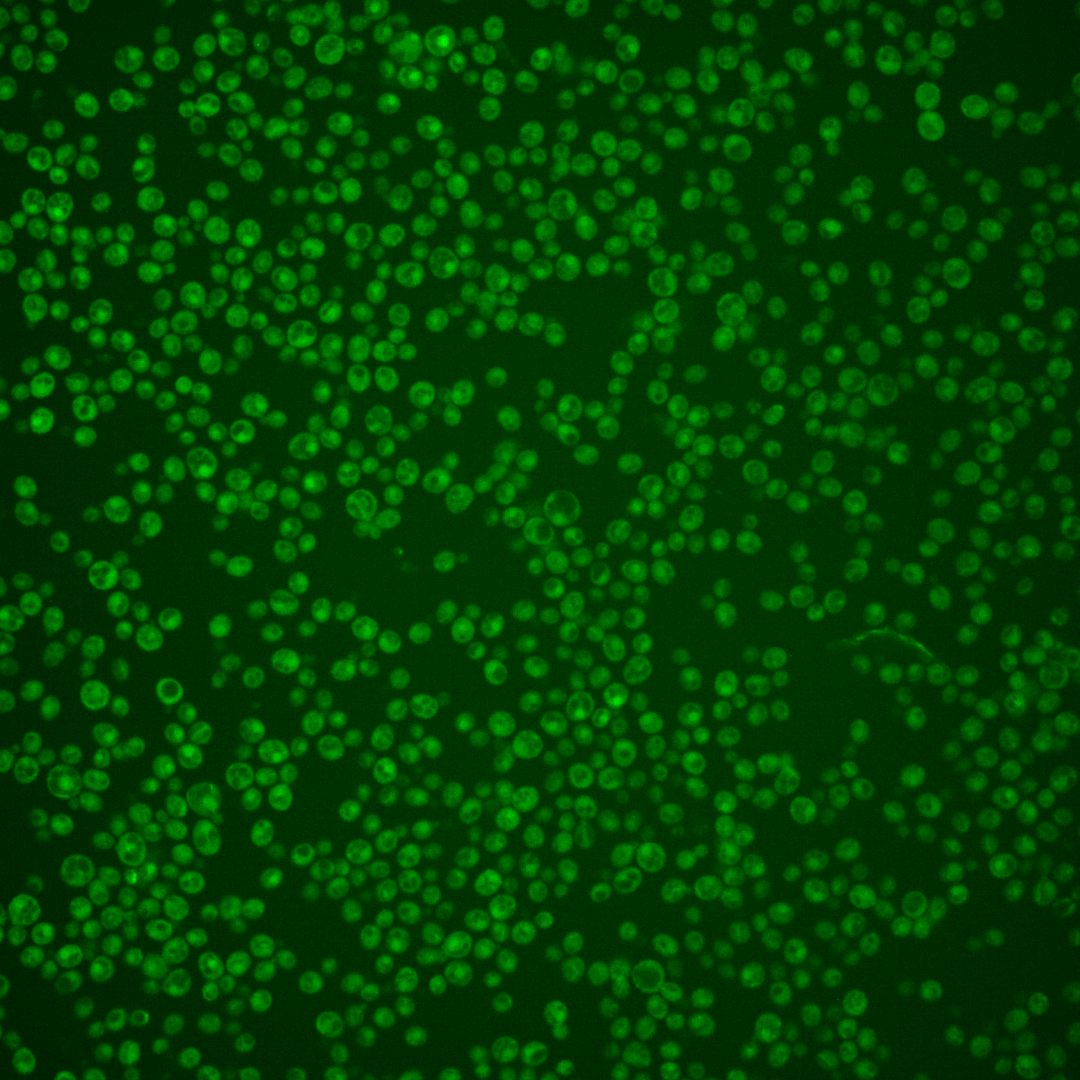

| Standard name | |
|---|---|
| Human Ortholog | |
| Description | Protein kinase; along with its paralog, ALK2, required for proper spindle positioning and nuclear segregation following mitotic arrest, proper organization of cell polarity factors in mitosis, proper localization of formins and polarity factors, and survival in cells that activate spindle assembly checkpoint; phosphorylated in response to DNA damage; ALK1 has a paralog, ALK2, that arose from the whole genome duplication; similar to mammalian haspins |
Micrographs




















































































Sub-cellular Localization
Yeast GFP Assignment
Protein Abundance
Localization Change
External localization resources
| ensLOC | DeepLoc | |||||||||||||||||||||||
|---|---|---|---|---|---|---|---|---|---|---|---|---|---|---|---|---|---|---|---|---|---|---|---|---|
| Localization | WT1 | WT2 | WT3 | RAP60 | RAP140 | RAP220 | RAP300 | RAP380 | RAP460 | RAP540 | RAP620 | RAP700 | HU80 | HU120 | HU160 | rpd3Δ_1 | rpd3Δ_2 | rpd3Δ_3 | WT1 | WT2 | WT3 | AF100 | AF140 | AF180 |
| Cortical Patches | 0 | 2 | 2 | 0 | 0 | 0 | 0 | 2 | 0 | 0 | 0 | 0 | 0 | 0 | 0 | – | 1 | 2 | 6 | 11 | 24 | 2 | 1 | 4 |
| Bud | 0 | 4 | 4 | 2 | 2 | 4 | 2 | 11 | 12 | 12 | 16 | 13 | 0 | 0 | 0 | – | 1 | 0 | 4 | 10 | 3 | 1 | 3 | 4 |
| Bud Neck | 1 | 0 | 1 | 0 | 2 | 0 | 0 | 1 | 1 | 1 | 0 | 0 | 1 | 1 | 1 | – | 1 | 0 | 5 | 13 | 14 | 1 | 0 | 0 |
| Bud Site | 0 | 0 | 0 | 0 | 0 | 1 | 0 | 0 | 1 | 1 | 3 | 1 | 0 | 0 | 0 | – | 0 | 0 | – | – | – | – | – | – |
| Cell Periphery | 8 | 16 | 21 | 6 | 8 | 4 | 6 | 7 | 7 | 6 | 9 | 13 | 0 | 0 | 5 | – | 17 | 30 | 6 | 11 | 25 | 1 | 0 | 0 |
| Cytoplasm | 152 | 315 | 263 | 174 | 265 | 353 | 284 | 361 | 210 | 278 | 235 | 222 | 121 | 121 | 188 | – | 225 | 249 | 130 | 251 | 156 | 77 | 176 | 192 |
| Endoplasmic Reticulum | 3 | 3 | 1 | 1 | 0 | 1 | 0 | 1 | 0 | 3 | 0 | 2 | 1 | 1 | 0 | – | 19 | 10 | 1 | 2 | 13 | 1 | 2 | 0 |
| Endosome | 0 | 1 | 3 | 0 | 5 | 2 | 5 | 5 | 2 | 3 | 2 | 3 | 0 | 0 | 0 | – | 3 | 2 | 0 | 5 | 3 | 0 | 1 | 2 |
| Golgi | 0 | 0 | 0 | 0 | 0 | 0 | 0 | 0 | 0 | 0 | 0 | 0 | 0 | 0 | 0 | – | 0 | 3 | 1 | 0 | 0 | 0 | 3 | 0 |
| Mitochondria | 2 | 12 | 11 | 17 | 17 | 173 | 124 | 231 | 190 | 359 | 259 | 265 | 0 | 0 | 0 | – | 8 | 8 | 9 | 11 | 24 | 5 | 6 | 10 |
| Nucleus | 1 | 1 | 0 | 4 | 0 | 0 | 0 | 4 | 0 | 3 | 1 | 2 | 2 | 2 | 1 | – | 1 | 1 | 0 | 1 | 0 | 0 | 0 | 0 |
| Nuclear Periphery | 0 | 0 | 0 | 4 | 1 | 0 | 0 | 0 | 3 | 4 | 0 | 1 | 0 | 0 | 0 | – | 0 | 0 | 0 | 0 | 1 | 0 | 0 | 0 |
| Nucleolus | 0 | 0 | 0 | 2 | 0 | 2 | 0 | 2 | 1 | 1 | 0 | 1 | 0 | 0 | 0 | – | 0 | 1 | 0 | 0 | 0 | 0 | 0 | 0 |
| Peroxisomes | 0 | 0 | 0 | 0 | 2 | 2 | 1 | 1 | 0 | 0 | 0 | 0 | 0 | 0 | 0 | – | 0 | 1 | 0 | 0 | 0 | 0 | 0 | 0 |
| SpindlePole | 0 | 0 | 0 | 0 | 0 | 3 | 4 | 9 | 7 | 9 | 12 | 12 | 0 | 0 | 0 | – | 1 | 0 | 1 | 1 | 0 | 0 | 2 | 3 |
| Vac/Vac Membrane | 1 | 0 | 3 | 3 | 6 | 6 | 8 | 7 | 4 | 11 | 8 | 8 | 0 | 0 | 0 | – | 5 | 0 | 3 | 6 | 4 | 1 | 3 | 4 |
| Unique Cell Count | 156 | 329 | 275 | 190 | 282 | 423 | 353 | 510 | 344 | 519 | 418 | 433 | 123 | 123 | 189 | 242 | 263 | 176 | 333 | 279 | 95 | 204 | 229 | |
| Labelled Cell Count | 168 | 354 | 309 | 213 | 308 | 551 | 434 | 642 | 438 | 691 | 545 | 543 | 125 | 125 | 195 | 282 | 307 | 176 | 333 | 279 | 95 | 204 | 229 | |
Yeast GFP Assignment
Protein Abundance
| Screen | WT1 | WT2 | WT3 | RAP60 | RAP140 | RAP220 | RAP300 | RAP380 | RAP460 | RAP540 | RAP620 | RAP700 | HU80 | HU120 | HU160 | rpd3Δ_1 | rpd3Δ_2 | rpd3Δ_3 | AF100 | AF140 | AF180 |
|---|---|---|---|---|---|---|---|---|---|---|---|---|---|---|---|---|---|---|---|---|---|
| Mean Cell GFP Intensity (1e-4) | 4.8 | 4.6 | 4.5 | 4.2 | 4.3 | 3.3 | 3.5 | 3.6 | 3.1 | 2.9 | 2.9 | 3.2 | 5.2 | 5.2 | 5.2 | 4.8 | 5.0 | 6.2 | 4.5 | 5.3 | 5.5 |
| Std Deviation (1e-4) | 1.7 | 1.4 | 1.7 | 2.1 | 2.1 | 1.5 | 1.9 | 1.7 | 1.0 | 0.9 | 0.9 | 1.5 | 1.0 | 1.0 | 1.1 | 1.5 | 1.5 | 2.2 | 1.1 | 1.9 | 1.9 |
| Intensity Change (Log2) | – | – | – | -0.09 | -0.06 | -0.43 | -0.34 | -0.31 | -0.53 | -0.62 | -0.64 | -0.49 | 0.22 | 0.22 | 0.22 | 0.12 | 0.17 | 0.47 | 0.02 | 0.26 | 0.3 |
Localization Change
| Localization | RAP60 | RAP140 | RAP220 | RAP300 | RAP380 | RAP460 | RAP540 | RAP620 | RAP700 | HU80 | HU120 | HU160 | rpd3Δ_1 | rpd3Δ_2 | rpd3Δ_3 |
|---|---|---|---|---|---|---|---|---|---|---|---|---|---|---|---|
| Actin | – | – | – | – | – | – | – | – | – | – | – | – | – | – | – |
| Bud | – | – | – | – | – | – | – | – | – | – | – | – | – | – | – |
| Bud Neck | – | – | – | – | – | – | – | – | – | – | – | – | – | – | – |
| Bud Site | – | – | – | – | – | – | – | – | – | – | – | – | – | – | – |
| Cell Periphery | – | – | – | – | – | – | – | – | – | – | – | – | – | – | – |
| Cyto | – | – | – | – | – | – | – | – | – | – | – | – | – | – | – |
| Endoplasmic Reticulum | – | – | – | – | – | – | – | – | – | – | – | – | – | – | – |
| Endosome | – | – | – | – | – | – | – | – | – | – | – | – | – | – | – |
| Golgi | – | – | – | – | – | – | – | – | – | – | – | – | – | – | – |
| Mitochondria | – | – | – | – | – | – | – | – | – | – | – | – | – | – | – |
| Nuclear Periphery | – | – | – | – | – | – | – | – | – | – | – | – | – | – | – |
| Nuc | – | – | – | – | – | – | – | – | – | – | – | – | – | – | – |
| Nucleolus | – | – | – | – | – | – | – | – | – | – | – | – | – | – | – |
| Peroxisomes | – | – | – | – | – | – | – | – | – | – | – | – | – | – | – |
| SpindlePole | – | – | – | – | – | – | – | – | – | – | – | – | – | – | – |
| Vac | – | – | – | – | – | – | – | – | – | – | – | – | – | – | – |
| Cortical Patches | – | – | – | – | – | – | – | – | – | – | – | – | – | – | – |
| Cytoplasm | – | – | – | – | – | – | – | – | – | – | – | – | – | – | – |
| Nucleus | – | – | – | – | – | – | – | – | – | – | – | – | – | – | – |
| Vacuole | – | – | – | – | – | – | – | – | – | – | – | – | – | – | – |
External localization resources
Images






























Protein Concentration and Protein Localization Data
| R1 | R2 | R3 | ||||||||||||||||
|---|---|---|---|---|---|---|---|---|---|---|---|---|---|---|---|---|---|---|
| G1 Pre-START | G1 Post-START | S/G2 | Metaphase | Anaphase | Telophase | G1 Pre-START | G1 Post-START | S/G2 | Metaphase | Anaphase | Telophase | G1 Pre-START | G1 Post-START | S/G2 | Metaphase | Anaphase | Telophase | |
| Concentration | 0.7715 | 0.4946 | 0.9188 | 1.2918 | 2.0554 | 1.065 | 1.9236 | 1.4808 | 1.9391 | 2.7228 | 2.6487 | 2.6616 | 1.1013 | 2.2777 | 2.1569 | 2.8336 | 3.2742 | 2.2724 |
| Actin | 0.0581 | 0.0039 | 0.0089 | 0.0005 | 0.0272 | 0.016 | 0.1581 | 0.001 | 0.0061 | 0.0005 | 0.0289 | 0.0112 | 0.0004 | 0.0003 | 0.001 | 0.0025 | 0.002 | 0.0095 |
| Bud | 0.0023 | 0.0118 | 0.0021 | 0.0002 | 0.0143 | 0.0039 | 0.0025 | 0.0002 | 0.0031 | 0.0001 | 0.0129 | 0.0005 | 0.0001 | 0.0001 | 0.0001 | 0.0029 | 0.0001 | 0.0007 |
| Bud Neck | 0.0039 | 0.0002 | 0.0006 | 0.0015 | 0.0018 | 0.0078 | 0.0025 | 0.001 | 0.0013 | 0.0005 | 0.0032 | 0.0015 | 0.0006 | 0.0002 | 0.0005 | 0.0025 | 0.0019 | 0.0029 |
| Bud Periphery | 0.0079 | 0.0051 | 0.0059 | 0.001 | 0.024 | 0.009 | 0.0041 | 0.0007 | 0.011 | 0.0003 | 0.0323 | 0.0021 | 0.0007 | 0.0002 | 0.0003 | 0.0051 | 0.0008 | 0.0016 |
| Bud Site | 0.0131 | 0.0203 | 0.008 | 0.0007 | 0.0057 | 0.0014 | 0.0095 | 0.0086 | 0.0045 | 0.0002 | 0.0025 | 0.0003 | 0.0009 | 0.0022 | 0.0007 | 0.0095 | 0.0005 | 0.001 |
| Cell Periphery | 0.0012 | 0.0015 | 0.0016 | 0.0048 | 0.0038 | 0.001 | 0.0005 | 0.001 | 0.0012 | 0.0023 | 0.004 | 0.0012 | 0.0035 | 0.0036 | 0.0032 | 0.0042 | 0.0143 | 0.0017 |
| Cytoplasm | 0.122 | 0.2632 | 0.2854 | 0.6301 | 0.5795 | 0.4073 | 0.1148 | 0.1966 | 0.2535 | 0.6674 | 0.6918 | 0.3974 | 0.2368 | 0.2361 | 0.4227 | 0.771 | 0.881 | 0.4592 |
| Cytoplasmic Foci | 0.016 | 0.0036 | 0.0159 | 0.0034 | 0.0177 | 0.0101 | 0.0236 | 0.0025 | 0.0086 | 0.0019 | 0.0154 | 0.0046 | 0.002 | 0.0017 | 0.002 | 0.0029 | 0.0023 | 0.002 |
| Eisosomes | 0.0006 | 0.0002 | 0.0003 | 0.0001 | 0.0003 | 0.0002 | 0.001 | 0.0001 | 0.0003 | 0.0001 | 0.0002 | 0.0001 | 0.0002 | 0.0003 | 0.0003 | 0.0001 | 0.0007 | 0.0001 |
| Endoplasmic Reticulum | 0.0045 | 0.0016 | 0.0031 | 0.0026 | 0.004 | 0.0022 | 0.0023 | 0.0008 | 0.0034 | 0.0032 | 0.0054 | 0.0013 | 0.0016 | 0.0012 | 0.0026 | 0.0031 | 0.0024 | 0.0015 |
| Endosome | 0.0194 | 0.0009 | 0.0116 | 0.0008 | 0.0536 | 0.0065 | 0.02 | 0.0005 | 0.0012 | 0.0004 | 0.0026 | 0.0071 | 0.0003 | 0.0002 | 0.0003 | 0.0005 | 0.0008 | 0.0002 |
| Golgi | 0.0109 | 0.0008 | 0.006 | 0.0002 | 0.0263 | 0.0019 | 0.0228 | 0.0001 | 0.0008 | 0.0001 | 0.0061 | 0.0032 | 0.0001 | 0.0001 | 0.0001 | 0.0003 | 0.0003 | 0.0001 |
| Lipid Particles | 0.0106 | 0.0002 | 0.0066 | 0.0002 | 0.0171 | 0.0026 | 0.018 | 0.0001 | 0.0025 | 0.0002 | 0.0159 | 0.0004 | 0.0003 | 0.0001 | 0.0002 | 0.0006 | 0.0002 | 0.0001 |
| Mitochondria | 0.0119 | 0.0002 | 0.0092 | 0.0001 | 0.0486 | 0.0016 | 0.0122 | 0.0001 | 0.0005 | 0.0001 | 0.0008 | 0.0009 | 0.0001 | 0.0001 | 0.0001 | 0.0003 | 0.0001 | 0.0001 |
| None | 0.6912 | 0.6833 | 0.6224 | 0.3519 | 0.1254 | 0.5118 | 0.5649 | 0.7854 | 0.6964 | 0.3211 | 0.1333 | 0.5616 | 0.7512 | 0.7522 | 0.5644 | 0.1897 | 0.0916 | 0.518 |
| Nuclear Periphery | 0.0113 | 0.0003 | 0.0009 | 0.0002 | 0.0074 | 0.0045 | 0.0011 | 0.0002 | 0.0003 | 0.0002 | 0.001 | 0.0002 | 0.0002 | 0.0001 | 0.0002 | 0.0005 | 0.0002 | 0.0002 |
| Nucleolus | 0.0006 | 0.0002 | 0.0003 | 0.0001 | 0.0034 | 0.0003 | 0.0002 | 0.0001 | 0.0002 | 0.0001 | 0.0001 | 0.0001 | 0.0001 | 0.0001 | 0.0001 | 0.0004 | 0 | 0 |
| Nucleus | 0.0025 | 0.0011 | 0.0007 | 0.0004 | 0.0126 | 0.003 | 0.0004 | 0.0004 | 0.0004 | 0.0004 | 0.0014 | 0.0003 | 0.0003 | 0.0004 | 0.0004 | 0.0015 | 0.0002 | 0.0003 |
| Peroxisomes | 0.005 | 0.0001 | 0.0057 | 0 | 0.0039 | 0.0043 | 0.0385 | 0.0001 | 0.0035 | 0 | 0.0394 | 0.0051 | 0 | 0 | 0.0001 | 0.0001 | 0.0001 | 0.0001 |
| Punctate Nuclear | 0.0034 | 0.0007 | 0.0014 | 0.0001 | 0.0134 | 0.0034 | 0.0014 | 0.0002 | 0.0005 | 0.0001 | 0.0009 | 0.0004 | 0.0002 | 0.0002 | 0.0002 | 0.0007 | 0.0001 | 0.0002 |
| Vacuole | 0.0023 | 0.0009 | 0.0026 | 0.001 | 0.0071 | 0.0008 | 0.0011 | 0.0005 | 0.0007 | 0.0008 | 0.0018 | 0.0003 | 0.0004 | 0.0005 | 0.0004 | 0.0016 | 0.0004 | 0.0002 |
| Vacuole Periphery | 0.0012 | 0.0001 | 0.0007 | 0 | 0.0031 | 0.0003 | 0.0005 | 0 | 0.0001 | 0 | 0.0002 | 0.0001 | 0 | 0 | 0 | 0.0001 | 0 | 0 |
Sequencing Data
| R1 | R2 | |||||||||
|---|---|---|---|---|---|---|---|---|---|---|
| G1 Post-START | S/G2 | Metaphase | Anaphase | Telophase | G1 Post-START | S/G2 | Metaphase | Anaphase | Telophase | |
| Gene Expression | 7.2497 | 38.0206 | 28.5336 | 25.6838 | 11.2795 | 4.3474 | 53.7323 | 52.3346 | 30.3194 | 14.7748 |
| Translational Efficiency | 0.7772 | 1.1132 | 1.2079 | 0.647 | 0.5397 | 1.0179 | 0.9161 | 0.7699 | 0.8996 | 0.7604 |
Hit Data
| Dataset | Hit |
|---|---|
| Protein Concentration | ✔ |
| Protein Localization | ✘ |
| Gene Expression | ✘ |
| Translational Efficiency | ✘ |
Micrographs
































Cell Count
| R1 | R2 | R1 & R2 | |||||||||
|---|---|---|---|---|---|---|---|---|---|---|---|
| WT | UBP2 | UBP14 | UBP2UBP14 | WT | UBP2 | UBP14 | UBP2UBP14 | WT | UBP2 | UBP14 | UBP2UBP14 |
| 163 | 1452 | 1082 | 1316 | 1509 | 1085 | 1871 | 1555 | 1672 | 2537 | 2953 | 2871 |
Protein Abundance
| R1 | R2 | R1 & R2 | ||||||||||
|---|---|---|---|---|---|---|---|---|---|---|---|---|
| WT | UBP2 | UBP14 | UBP2UBP14 | WT | UBP2 | UBP14 | UBP2UBP14 | WT | UBP2 | UBP14 | UBP2UBP14 | |
| Mean | 862.15 | 758.52 | 834.09 | 1049.38 | 695.24 | 717.56 | 861.13 | 1071.67 | 711.51 | 741.00 | 851.22 | 1061.45 |
| Standard Deviation | 119.47 | 113.75 | 101.91 | 163.57 | 83.19 | 92.01 | 114.01 | 158.72 | 100.44 | 106.94 | 110.50 | 161.35 |
| Intensity Change Log 2 | — | -0.184752 | -0.047736 | 0.283526 | — | 0.045588 | 0.308720 | 0.624278 | — | -0.077359 | 0.122342 | 0.445648 |
Localization Score (DeepLoc)
| R1 | R2 | R1 & R2 | ||||||||||
|---|---|---|---|---|---|---|---|---|---|---|---|---|
| WT | UBP2 | UBP14 | UBP2UBP14 | WT | UBP2 | UBP14 | UBP2UBP14 | WT | UBP2 | UBP14 | UBP2UBP14 | |
| Actin | 0.001203 | 0.000368 | 0.000379 | 0.039843 | 0.000428 | 0.001063 | 0.001331 | 0.026194 | 0.000503 | 0.000665 | 0.000982 | 0.032450 |
| Bud Neck | 0.007681 | 0.021772 | 0.003702 | 0.022384 | 0.022982 | 0.044854 | 0.007918 | 0.020617 | 0.021490 | 0.031644 | 0.006373 | 0.021427 |
| Bud Site | 0.043362 | 0.017255 | 0.011686 | 0.188043* | 0.007805 | 0.015540 | 0.033543 | 0.144141* | 0.011271 | 0.016521 | 0.025534 | 0.164265* |
| Cell Periphery | 0.000487 | 0.000306 | 0.000343 | 0.013679 | 0.000328 | 0.001015 | 0.000709 | 0.008633 | 0.000344 | 0.000610 | 0.000575 | 0.010946 |
| Cytoplasm | 0.270090* | 0.540998* | 0.526517* | 0.399605* | 0.469682* | 0.417317* | 0.593670* | 0.450077* | 0.450224* | 0.488103* | 0.569065* | 0.426942* |
| Cytoplasmic Foci | 0.099396 | 0.169016 | 0.034655 | 0.039622 | 0.218004* | 0.260416* | 0.029402 | 0.039224 | 0.206441* | 0.208105* | 0.031327 | 0.039406 |
| Eisosomes | 0.000192 | 0.000286 | 0.000074 | 0.003588 | 0.000695 | 0.000709 | 0.000197 | 0.002511 | 0.000646 | 0.000467 | 0.000152 | 0.003005 |
| Endoplasmic Reticulum | 0.001787 | 0.000962 | 0.002199 | 0.005967 | 0.001336 | 0.000442 | 0.002579 | 0.005956 | 0.001380 | 0.000739 | 0.002440 | 0.005961 |
| Endosome | 0.034099 | 0.013286 | 0.002695 | 0.002271 | 0.010449 | 0.022618 | 0.001495 | 0.004538 | 0.012754 | 0.017277 | 0.001935 | 0.003499 |
| Golgi | 0.023099 | 0.003166 | 0.000111 | 0.003252 | 0.003340 | 0.006658 | 0.000179 | 0.003859 | 0.005266 | 0.004660 | 0.000154 | 0.003581 |
| Lipid Particles | 0.005624 | 0.004275 | 0.001617 | 0.010371 | 0.011451 | 0.009831 | 0.001027 | 0.004154 | 0.010883 | 0.006651 | 0.001243 | 0.007004 |
| Mitochondria | 0.000754 | 0.002878 | 0.000318 | 0.001643 | 0.005039 | 0.013105 | 0.000459 | 0.004008 | 0.004622 | 0.007252 | 0.000407 | 0.002924 |
| Mitotic Spindle | 0.008317 | 0.004613 | 0.002326 | 0.012985 | 0.000726 | 0.005176 | 0.001822 | 0.010237 | 0.001466 | 0.004854 | 0.002007 | 0.011497 |
| None | 0.000342 | 0.005335 | 0.003982 | 0.001072 | 0.002263 | 0.003596 | 0.002389 | 0.002709 | 0.002076 | 0.004591 | 0.002973 | 0.001959 |
| Nuclear Periphery | 0.000520 | 0.000533 | 0.000722 | 0.000210 | 0.000414 | 0.000263 | 0.000352 | 0.000245 | 0.000424 | 0.000418 | 0.000488 | 0.000229 |
| Nuclear Periphery Foci | 0.001349 | 0.000812 | 0.001869 | 0.003224 | 0.000397 | 0.000229 | 0.001712 | 0.003545 | 0.000490 | 0.000562 | 0.001770 | 0.003398 |
| Nucleolus | 0.000262 | 0.001134 | 0.000447 | 0.000115 | 0.001002 | 0.001231 | 0.000121 | 0.000106 | 0.000930 | 0.001175 | 0.000240 | 0.000110 |
| Nucleus | 0.104082 | 0.136724* | 0.337079* | 0.074094 | 0.173669* | 0.108134 | 0.217293* | 0.081787 | 0.166885* | 0.124497 | 0.261184* | 0.078261 |
| Peroxisomes | 0.009742 | 0.006722 | 0.000341 | 0.003415 | 0.005996 | 0.017974 | 0.000408 | 0.002765 | 0.006362 | 0.011534 | 0.000383 | 0.003063 |
| Vacuole | 0.379891* | 0.068378 | 0.068775 | 0.172824 | 0.063125 | 0.068001 | 0.103160 | 0.182667 | 0.094006 | 0.068217 | 0.090561 | 0.178156 |
| Vacuole Periphery | 0.007719 | 0.001179 | 0.000162 | 0.001791 | 0.000870 | 0.001831 | 0.000233 | 0.002027 | 0.001538 | 0.001458 | 0.000207 | 0.001919 |
Localization Changes (T-score)
| R1 | R2 | R1 & R2 | |||||||||||||
|---|---|---|---|---|---|---|---|---|---|---|---|---|---|---|---|
| UBP2_WT | UBP14_WT | UBP2UBP14_WT | UBP2UBP14_UBP2 | UBP2UBP14_UBP14 | UBP2_WT | UBP14_WT | UBP2UBP14_WT | UBP2UBP14_UBP2 | UBP2UBP14_UBP14 | UBP2_WT | UBP14_WT | UBP2UBP14_WT | UBP2UBP14_UBP2 | UBP2UBP14_UBP14 | |
| Actin | 1.83 | 1.69 | -13.68 | -14.05 | -14.03 | -1.46 | -6.60 | -11.87 | -10.85 | -11.18 | -1.00 | -4.80 | -18.23 | -17.86 | -17.79 |
| Bud Neck | -6.80 | 0.75 | -7.18 | 0.65 | -13.70 | -6.42 | 9.89 | 3.33 | 8.51 | -7.55 | -4.93 | 10.95 | 1.78 | 7.24 | -13.88 |
| Bud Site | 1.40 | 2.10 | -11.07 | -21.92 | -22.71* | -4.05 | -8.02 | -20.83 | -18.27 | -14.40 | -3.88 | -5.84 | -29.81 | -28.23 | -25.40 |
| Cell Periphery | 0.29 | 0.08 | -9.45 | -9.63 | -9.59 | -1.10 | -6.15 | -9.63 | -5.03 | -8.96 | -1.03 | -4.82 | -13.29 | -11.05 | -12.87 |
| Cytoplasm | -12.12 | -9.77 | -2.78 | 20.25 | 14.03 | 5.11 | -8.31 | 9.62 | 3.46 | 17.57 | -4.44 | -9.31 | 11.45 | 17.20 | 23.20 |
| Cytoplasmic Foci | -9.72 | 5.33 | 3.60 | 22.35 | -4.02 | -5.03 | 35.84 | 29.38 | 29.94 | -7.40 | -0.58 | 35.23 | 30.12 | 36.26 | -8.44 |
| Eisosomes | -1.98 | 1.80 | -8.77 | -8.32 | -9.30 | -0.04 | 6.03 | -3.84 | -3.15 | -6.99 | 1.72 | 6.54 | -7.23 | -8.39 | -11.49 |
| Endoplasmic Reticulum | 2.68 | -3.06 | -10.68 | -13.15 | -8.08 | 5.23 | -7.56 | -7.09 | -8.92 | -3.67 | 3.65 | -7.83 | -11.84 | -14.23 | -7.36 |
| Endosome | 1.82 | 4.16 | 4.29 | 9.04 | 1.93 | -6.79 | 12.33 | 7.90 | 11.18 | -4.31 | -4.45 | 12.12 | 10.26 | 13.97 | -3.42 |
| Golgi | 1.68 | 2.19 | 1.90 | 1.52 | -2.01 | -3.61 | 10.88 | 1.87 | 4.23 | -2.57 | -0.40 | 6.52 | 2.97 | 4.01 | -3.23 |
| Lipid Particles | -0.22 | 1.45 | -3.01 | -4.31 | -6.57 | 1.26 | 12.50 | 7.07 | 4.34 | -9.99 | 4.53 | 12.28 | 3.76 | -0.66 | -9.81 |
| Mitochondria | -4.38 | 0.86 | -1.47 | 3.09 | -2.17 | -4.07 | 6.57 | 3.15 | 5.67 | -2.59 | -2.46 | 6.65 | 4.11 | 6.12 | -3.20 |
| Mitotic Spindle | 0.29 | 1.09 | -3.65 | -5.36 | -6.41 | -2.95 | -2.27 | -6.65 | -3.82 | -5.98 | -3.58 | -1.34 | -9.38 | -6.56 | -8.83 |
| None | -5.15 | -6.50 | -4.24 | 4.31 | 4.81 | -1.14 | 0.18 | 0.26 | 1.29 | 0.18 | -2.95 | -1.16 | 0.74 | 3.80 | 2.69 |
| Nuclear Periphery | 0.41 | -3.40 | -0.54 | -0.61 | 3.50 | 2.52 | -1.86 | -4.22 | -8.48 | -3.70 | 0.16 | -4.14 | -4.30 | -2.09 | -0.98 |
| Nuclear Periphery Foci | 1.63 | -2.77 | -7.73 | -8.37 | -6.47 | 2.18 | -9.67 | -11.68 | -12.22 | -8.93 | -0.39 | -10.28 | -14.26 | -13.81 | -10.81 |
| Nucleolus | -5.39 | -3.00 | -1.06 | 4.92 | 1.95 | -0.58 | 5.77 | 3.74 | 2.80 | -4.44 | -1.11 | 4.96 | 4.16 | 5.19 | -2.10 |
| Nucleus | -1.61 | -13.11 | 1.00 | 8.09 | 27.69 | 10.35 | -10.67 | 12.02 | 0.32 | 22.07 | 8.20 | -18.70 | 13.75 | 6.06 | 34.80 |
| Peroxisomes | -0.34 | 2.03 | 1.11 | 4.36 | -6.29 | -7.28 | 11.05 | 6.02 | 9.83 | -6.50 | -5.61 | 10.64 | 5.87 | 10.45 | -9.04 |
| Vacuole | 14.42 | 13.58 | 6.50 | -25.76 | -21.47 | -1.63 | -15.51 | -31.13 | -28.76 | -18.80 | 6.48 | -3.44 | -27.13 | -38.78 | -27.37 |
| Vacuole Periphery | 1.45 | 1.90 | 1.53 | 0.50 | -1.81 | -3.37 | 5.00 | -0.28 | 1.63 | -1.85 | -0.79 | 4.22 | 0.65 | 1.40 | -2.56 |
Endocytosis
| Temp | Actin Patch (Sac6-tdTomato) | Cortical Patch (Sla1-GFP) | Late Endosome (Snf7-GFP) | Vacuole (Vph1-GFP) |
|---|---|---|---|---|
| 37℃ | ||||
| RT |
Cell Cycle Omics
CYCLoPs (Alk1-GFP)
| Gene / Allele | Actin Patch (Sac6-tdTomato) | Cortical Patch (Sla1-GFP) | Late Endosome (Snf7-GFP) | Vacuole (Sac6-tdTomato) |
|---|
| Gene | Images |
|---|
| Gene | Images |
|---|
Images are not yet available
Images are not yet available